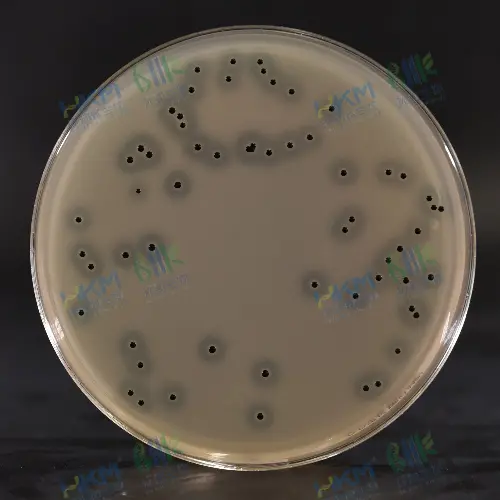
BP琼脂
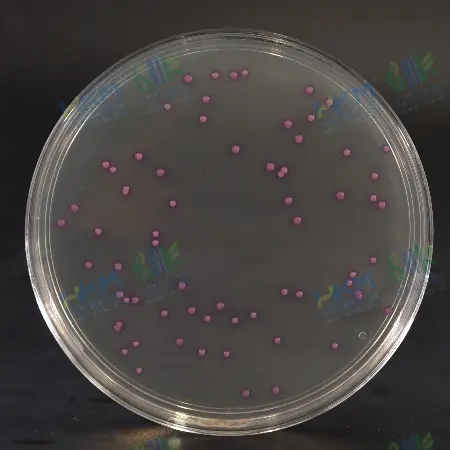
金黄色葡萄球菌显色培养基
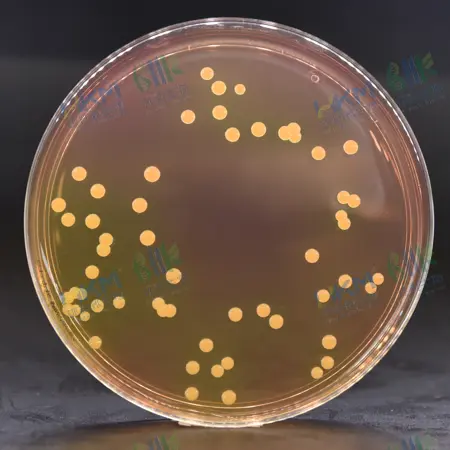
甘露醇高盐琼脂
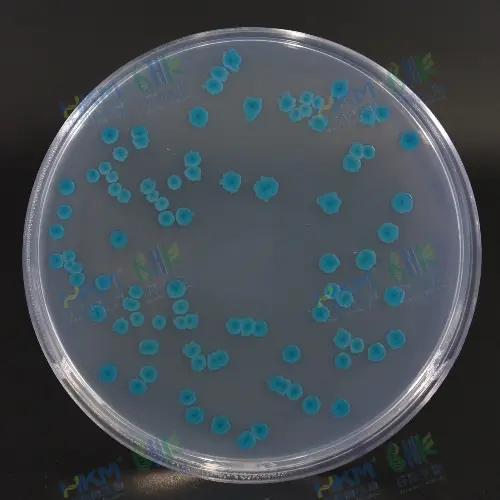
大肠杆菌显色培养基
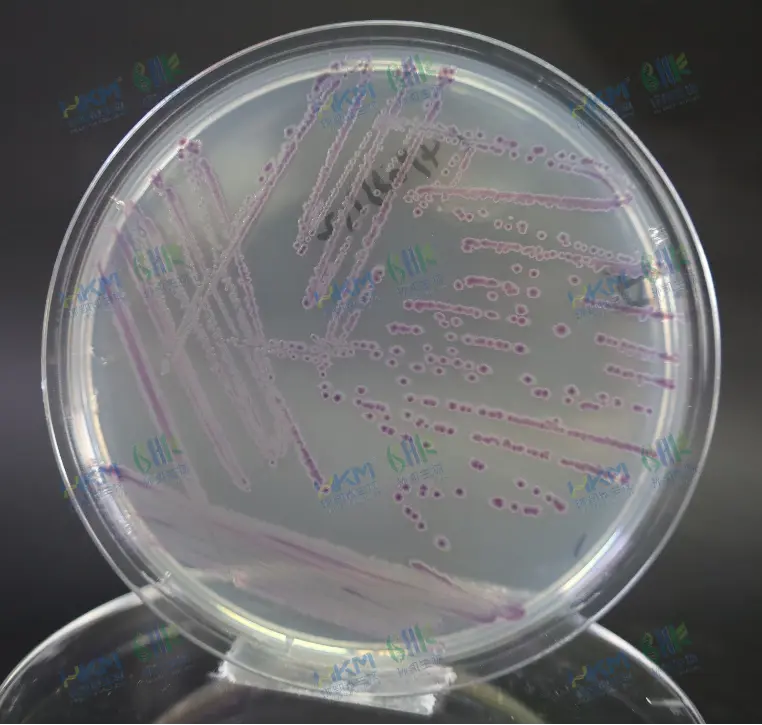
O157显色培养基
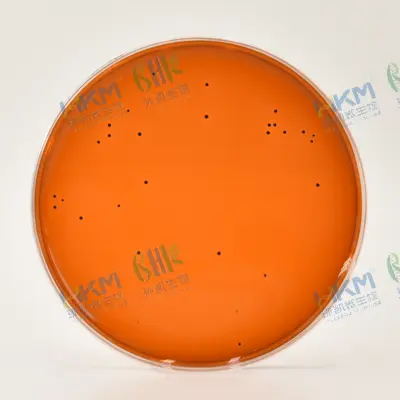
伊红美蓝琼脂（EMB）
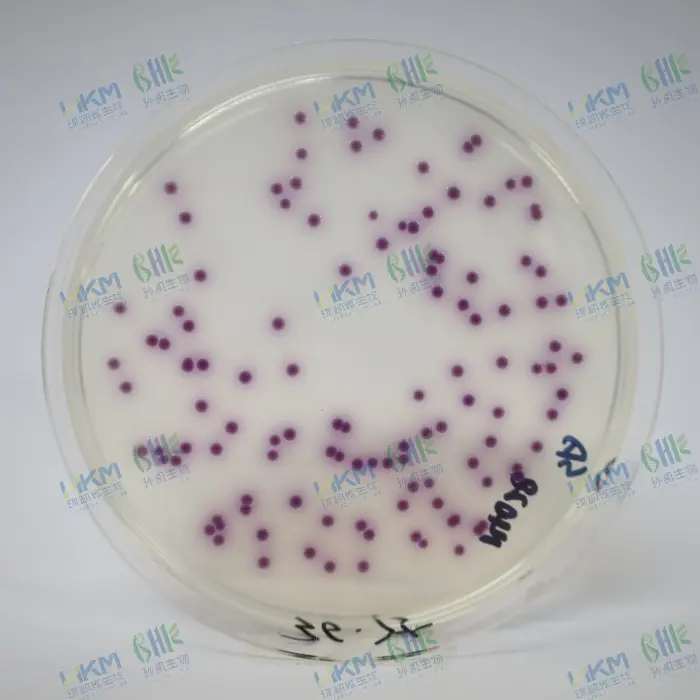
沙门氏菌显色培养基
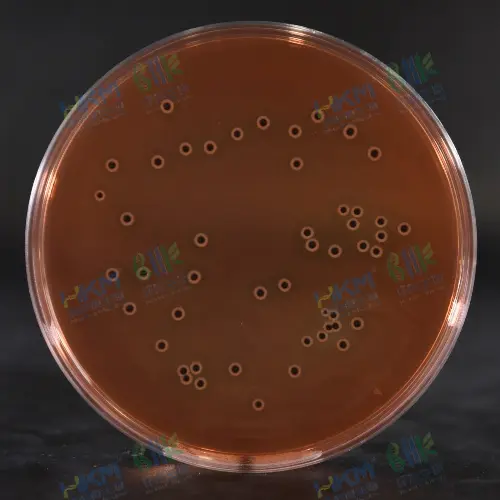
DHL琼脂
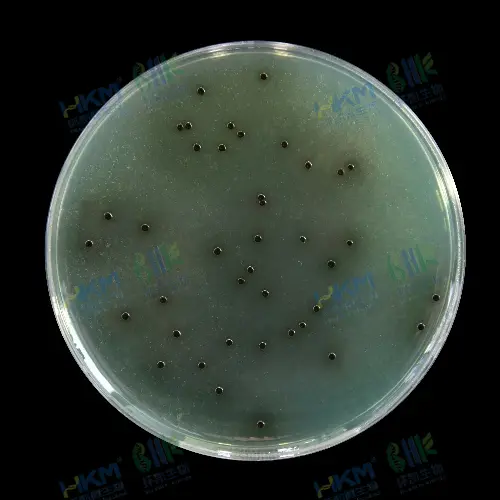
亚硫酸铋琼脂（BS）
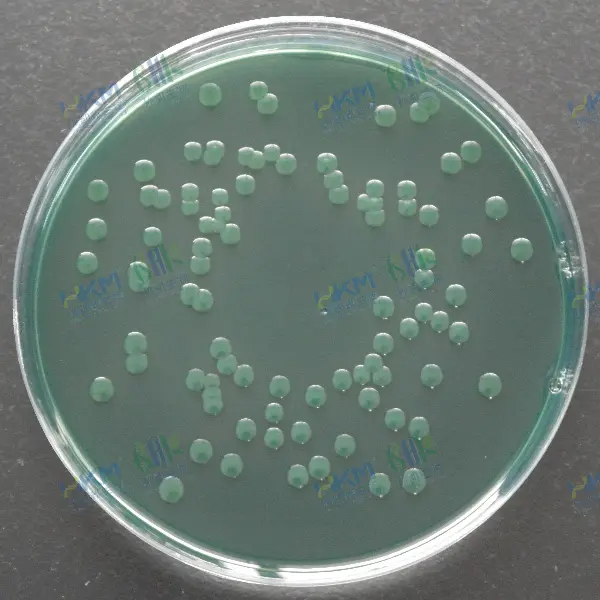
TCBS培养基
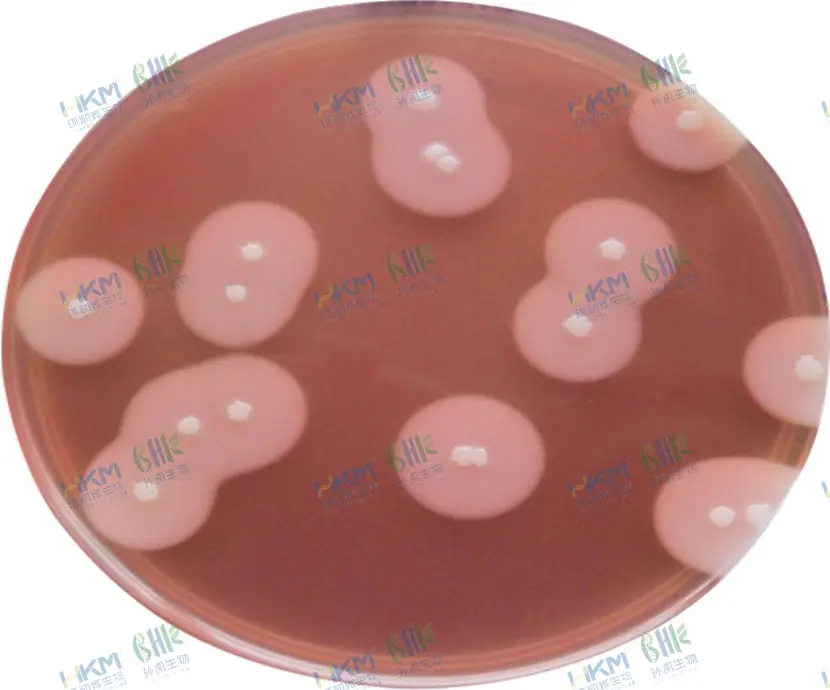
MYP琼脂
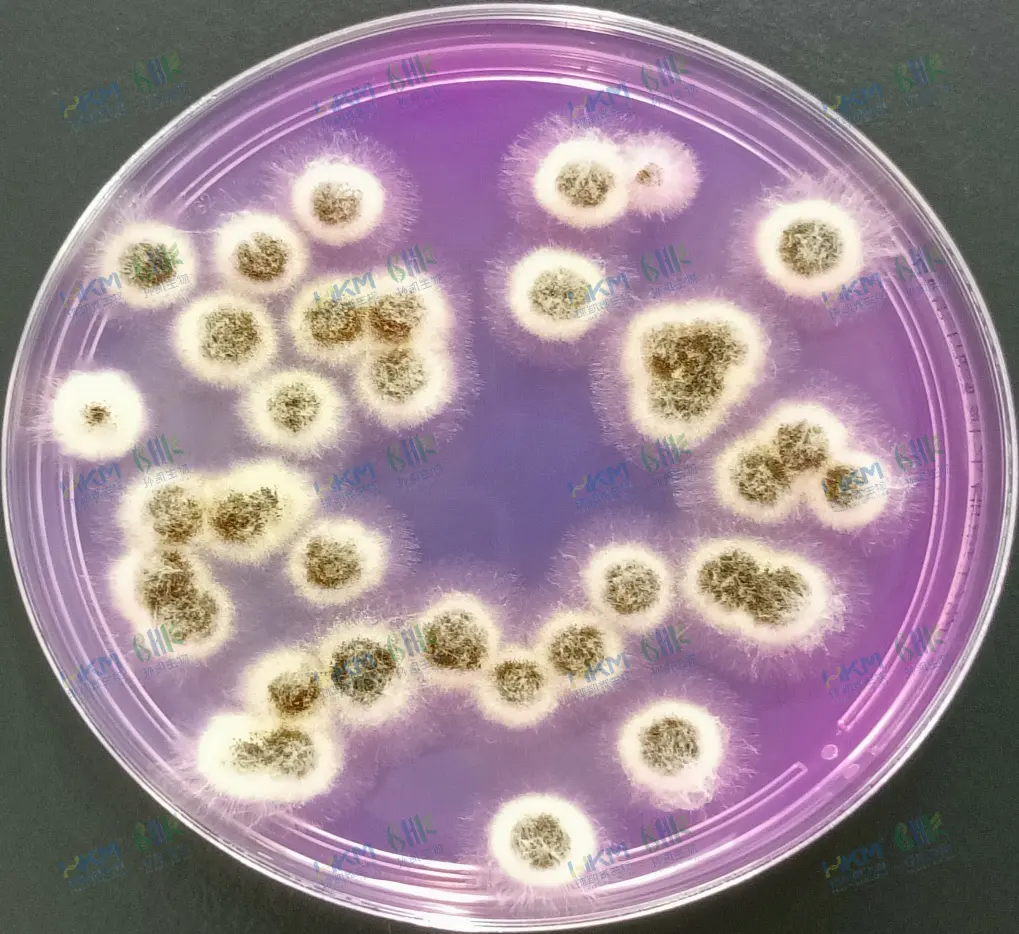
孟加拉红培养基
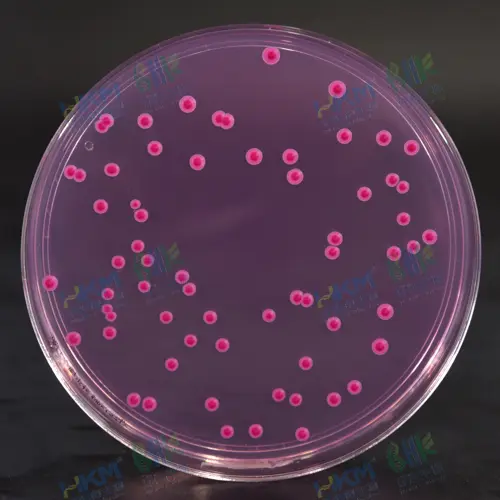
孟加拉红培养基：红色菌落
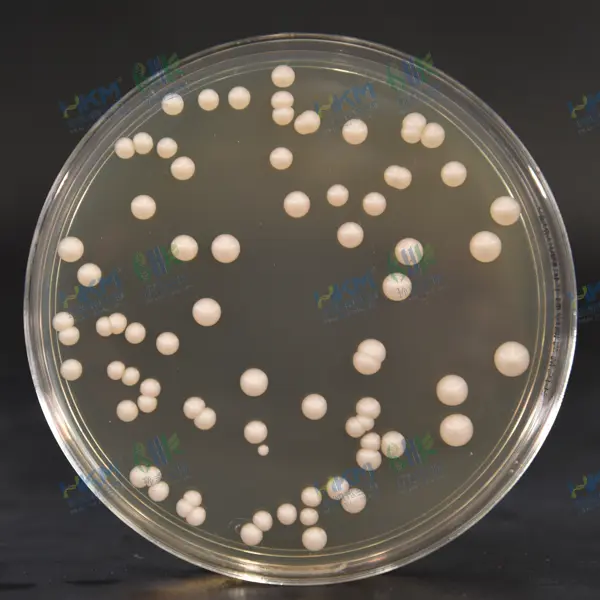
铃薯葡萄糖琼脂

微生物在不同培养基上的菌落形态特征及比较
发布时间:2025-02-20 浏览次数:19881
一、细菌类
1、金黄色葡萄球菌
BP琼脂:菌落呈圆形,表面光滑、凸起、湿润,直径2-3mm,灰黑色至黑色,边缘浅色,周围有不透明圈(沉淀)和清晰带(卵磷脂环),触感如黄油般粘稠。
金黄色葡萄球菌显色培养基:粉红色至紫红色的菌落,若未显色需延长培养时间。
甘露醇高盐琼脂:黄色菌落,外围黄色晕环。
2、大肠杆菌
大肠杆菌显色培养基:蓝色至紫色菌落(大肠杆菌),粉红色菌落(大肠菌群),其他细菌无色。
O157显色培养基:O157:H7 菌株显紫色,普通大肠杆菌显暗蓝色。
伊红美蓝琼脂(EMB):黑色中心,可能带金属光泽。
3、沙门氏菌
沙门氏菌显色培养基:沙门氏菌呈品红(紫红)色的菌落,大肠菌群呈蓝绿色的菌落。
DHL琼脂:无色半透明菌落,中心黑色。
亚硫酸铋琼脂(BS):棕褐色至黑色,有金属光泽,周围培养基变暗。
4、副溶血性弧菌
TCBS培养基:蓝绿色圆形菌落,边缘整齐,直径2-4mm;霍乱弧菌为黄色扁平菌落。
5、蜡样芽孢杆菌
MYP琼脂:白色菌落,外围粉红色晕环。
二、霉菌与酵母菌
1、霉菌
孟加拉红培养基:灰色菌落,表面有黑色孢子。
菌落特征:疏松绒毛状或棉絮状,不易挑起,颜色多样(棕、青等)。
2、酵母菌
孟加拉红培养基:红色菌落。
马铃薯葡萄糖琼脂:乳白色菌落,有突起。
菌落特征:湿润、粘稠,比细菌菌落大而厚。
三、菌落形态四大类比较
| 微生物类型 | 菌落特征 | 典型颜色与结构 |
| 细菌 | 湿润、粘稠、易挑起,圆形光滑 | 白、黄、灰黑 (如金黄色葡萄球菌) |
| 放线菌 | 干燥、多皱、难挑起, 背面有同心圆纹路 | 多有色素(如灰绿、橙红) |
| 酵母菌 | 湿润、黏稠、半透明,比细菌大 | 乳白、淡黄、红色 (孟加拉红) |
| 霉菌 | 疏松绒毛状/蜘蛛网状, 菌丝细长,孢子明显 | 灰、青、棕,黑色孢子群 |
微生物菌落形态的识别需结合培养基类型、培养时间及菌落特征(颜色、透明度、边缘结构等)。显色培养基通过生化反应显色,特异性强;传统培养基(如EMB、TCBS)依赖代谢产物颜色变化。实际检测中,需注意菌株变异或储存条件对菌落外观的影响(如长期冷冻的金葡菌颜色变浅)。
